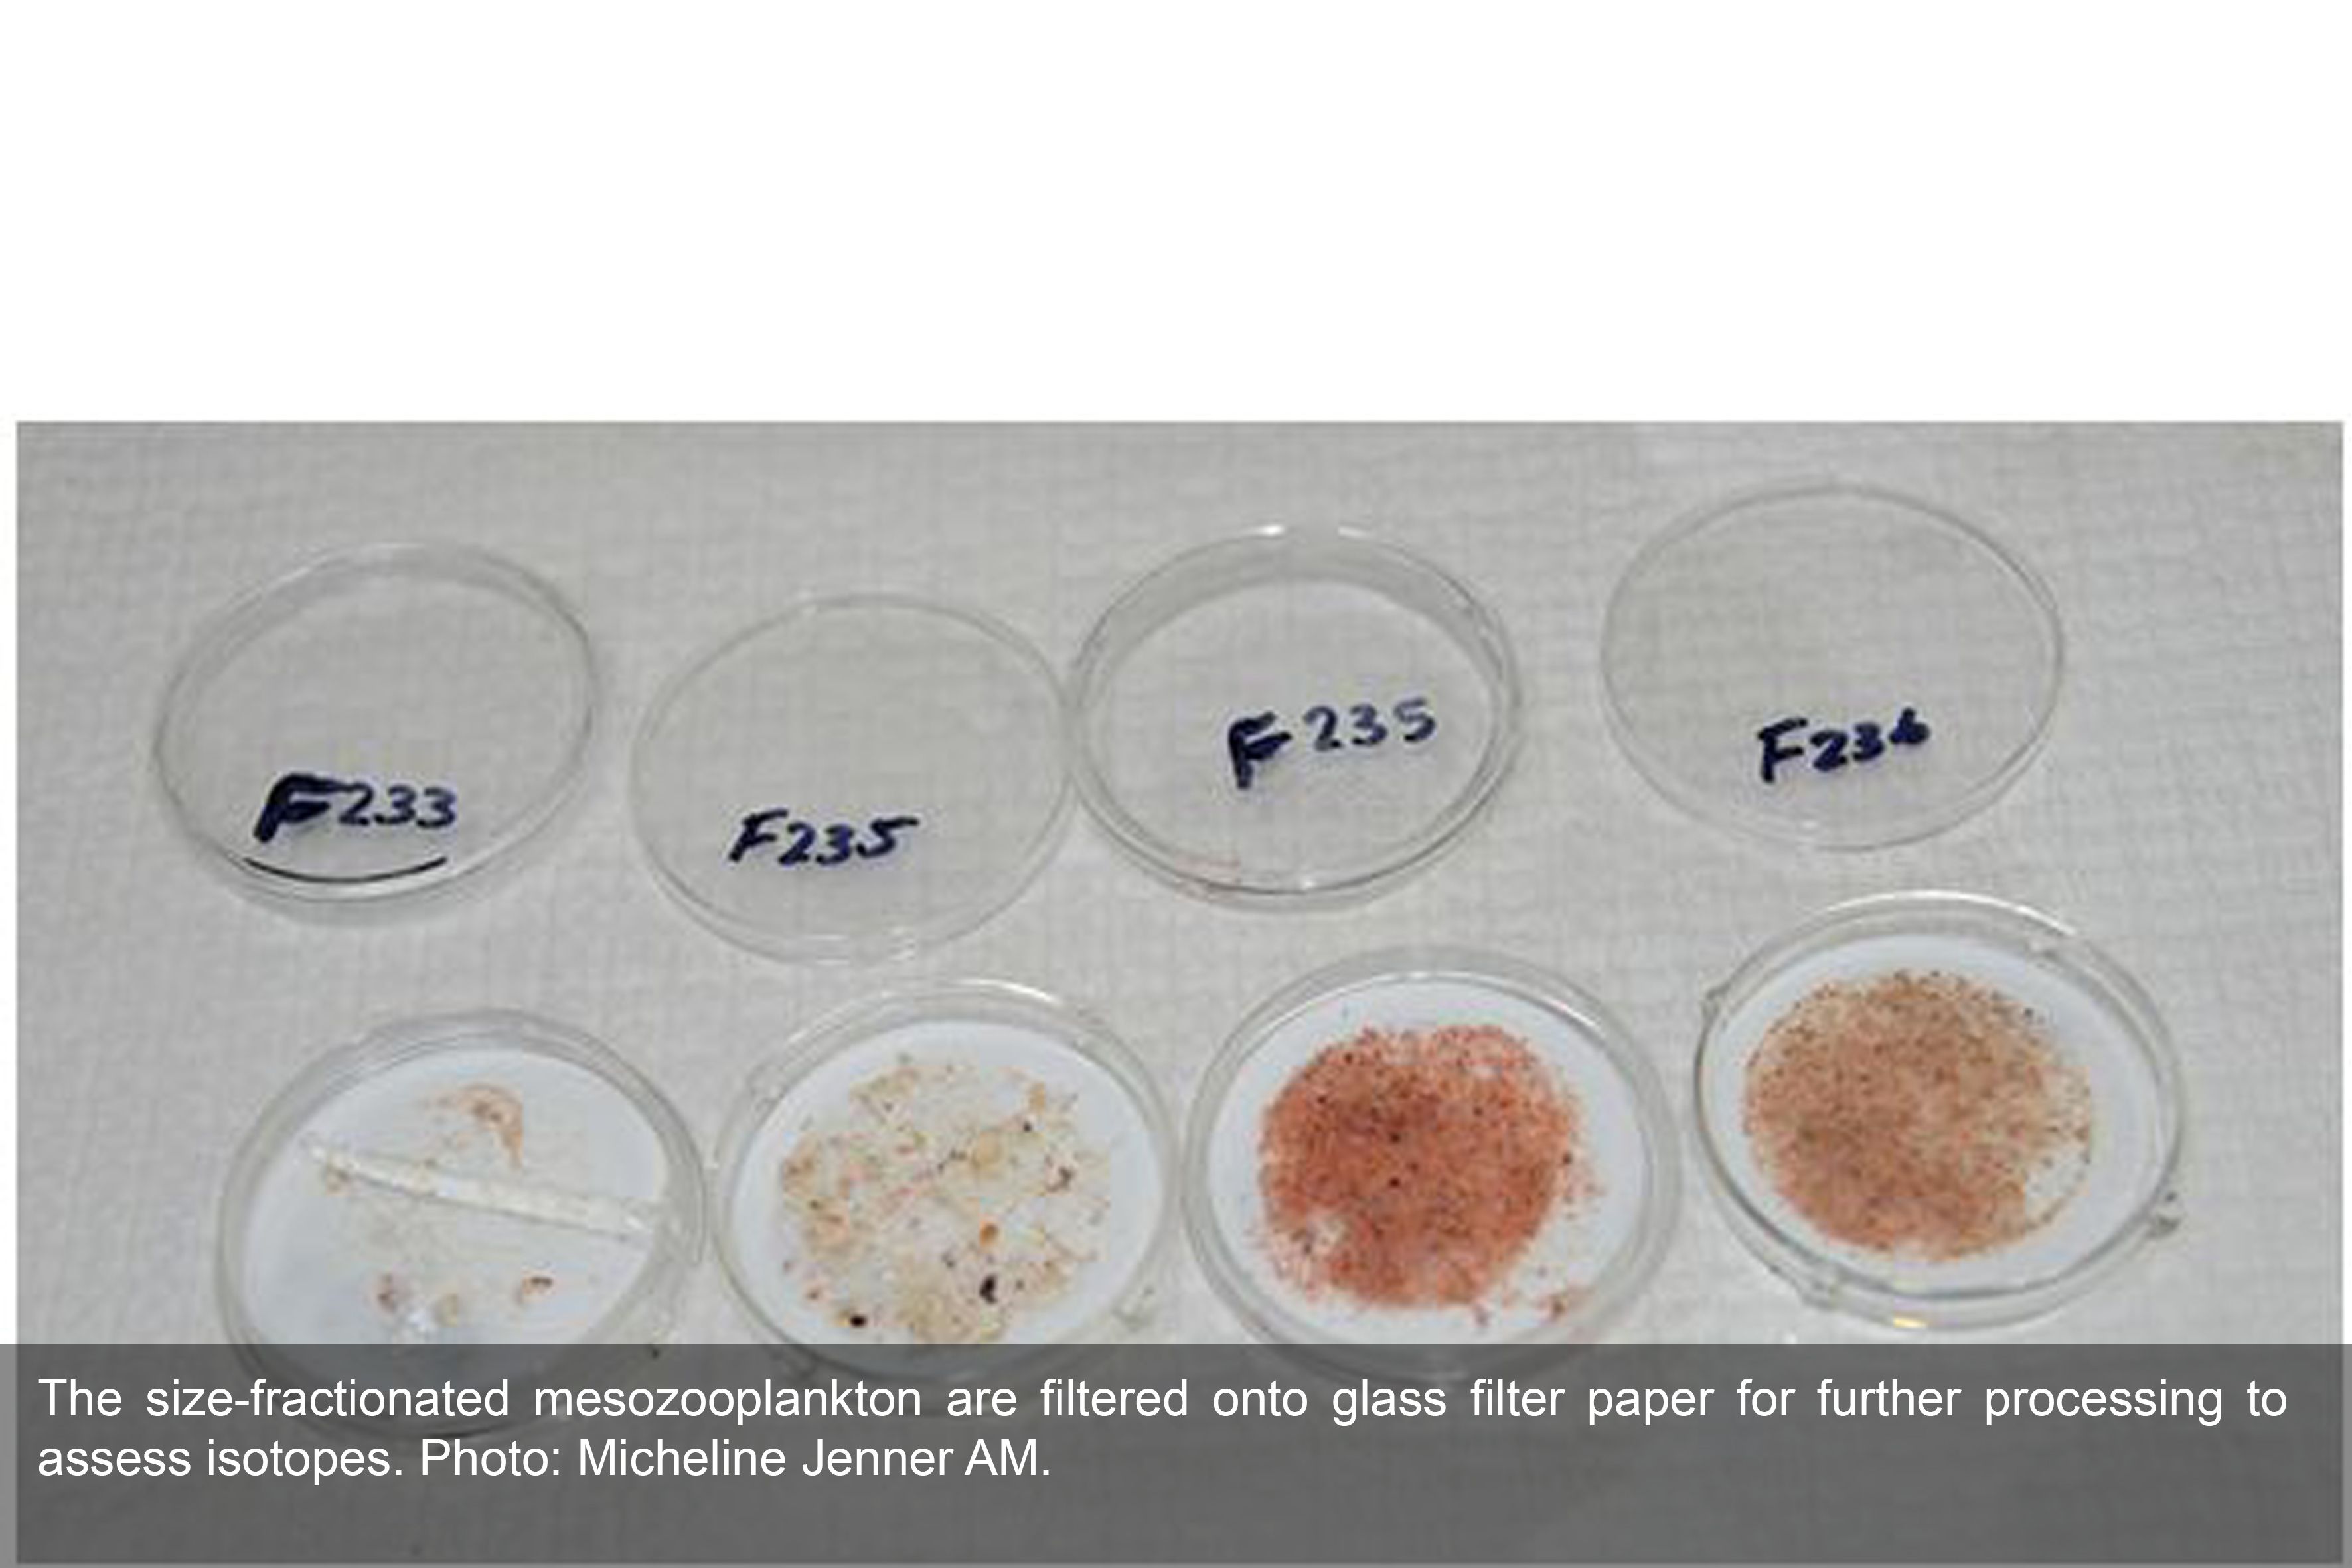

The RV Investigator is currently undertaking oceanographic research along the 110°E meridian off Western Australia as part of the second International Indian Ocean Expedition. The voyage is led by Professor Lynnath Beckley of Murdoch University and the research is supported by a grant of sea time on RV Investigator from the CSIRO Marine National Facility.
|
Date: June 03, 2019 |
Time: 1200 AWST |
|
Latitude: 14°S |
Longitude: 110°E |
|
Wind direction: ESE |
Wind speed:17 knots |
|
Swell direction: ENE 2m, ESE 2m |
Depth: 5715 m |
|
Air temperature: 27°C |
Sea temperature: 28°C |
|
Notes: At Station 17 of 20 on the 110°East line, we are in some of the deepest water so far |
|
Direct measurements of phytoplankton growth and grazing by micro- and mesozooplankton are one way to look at variability in trophic structure in our study region (e.g., how many steps are mesozooplankton removed on average from phytoplankton). Analyses of bulk nitrogen and carbon isotopes from the size-fractioned mesozooplankton net tows will also provide an independent check on these estimates. Trophic information from isotopes comes from the fact that the lighter and more abundant isotope of nitrogen (14N) is selectively utilized by organisms when they metabolize, so the remaining proteins in animal tissues get enriched in the heavier isotope 15N. There's a saying for this, "You are what you eat plus 3.4 parts per thousand 15N", which captures the notion that this particular relationship has been widely applied in food web studies of both aquatic and land systems.
An additional important goal of our study is to use isotopes to determine how the food web may have changed over the five decades since the first International Indian Ocean Expedition (IIOE). This cannot be done by standard bulk isotope method which would require separate sampling for phytoplankton isotopes which vary substantially depending on whether the main source of N to the food web is nitrate mixed upward from deep water or fixed N2 gas from the atmosphere (or some combination). Instead, we will use a relatively new technique called Compound-Specific Isotopic Composition of Amino Acids (CSIA-AA), which relies on differences in isotopic enrichment of individual amino acids to provide information. A group of source AAs retains 15N enrichment values similar to the baseline value of N. Another group of trophic AAs enriches very strongly with each trophic transfer step. The fact that N isotopic composition doesn't change much with long-term preservation in formalin means we can use historical IIOE samples collected at the same stations and same time of year in the 1960s to compare N sources and trophic structure for the same dominant species sorted from the samples.
Be sure to follow our daily Log from One Ten East at https://iioe-2.incois.gov.in and https://wamsi.org.au